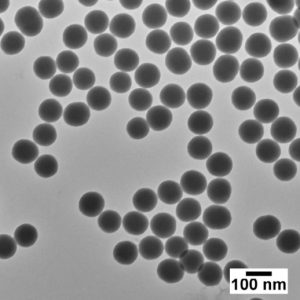

NanoXact Silica Nanospheres
Silica nanospheres with a bare surface (standard) are monodisperse with diameters 20 nm and up.
NanoXact materials are high quality, unagglomerated and monodisperse nanoparticles.
Available Diameter
20 nm 50 nm 60nm 80nm 100nm 120nm 200nm 300nm 500nm 1 µm
Concentration
5 mg/mL in water
Availabale Volume
25 mL 100 mL 500 mL 1 L
+91-8800903073, 8452810712